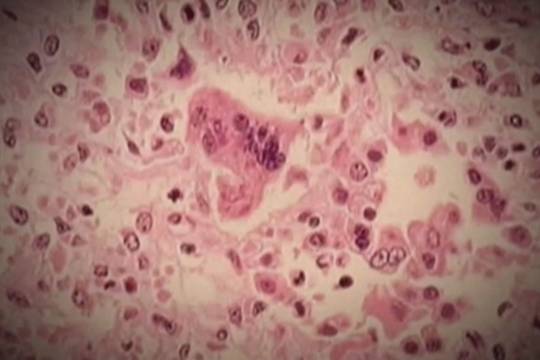

卡尔加里地区确诊麻疹病例引起公众警惕
在卡尔加里地区确认了一例麻疹病例后,艾伯塔省卫生服务局(AHS)发布了一项公共警报,该病例可能导致其他人接触麻疹。

警报于周五晚上发布。美国AHS的一名代表告诉《环球新闻》,目前已有一人被确诊,他们在感染期间曾在以下地点公开露面。
2025年3月8日,Airdrie超市,退伍军人大道300号不,艾尔德里。暴露时间:大约下午2点至3点2025年3月9日,新地平线购物中心-天空城堡家庭娱乐中心和自助餐厅。260300 Writing Creek Cresc。轻木。暴露时间:约中午12点至下午3点2025年3月11日,Airdrie急救中心,主街604号,airdrii。暴露时间:约下午三点半至晚上七时2025年3月12日One Health Associate Medical Clinic. 836 . 1 Ave. NW, #201, airdrive。暴露时间:约上午9时至10时30分 获取每周健康资讯每周日为您提供最新的医学新闻和健康资讯。注册每周健康通讯注册通过提供您的电子邮件地址,您已阅读并同意环球新闻的条款和条件以及隐私政策。
获取每周健康资讯每周日为您提供最新的医学新闻和健康资讯。注册每周健康通讯注册通过提供您的电子邮件地址,您已阅读并同意环球新闻的条款和条件以及隐私政策。
美国卫生协会建议,1970年或之后出生的人在那段时间去过这些地方,监测咳嗽、流鼻涕、红眼和发烧等麻疹症状。
下面的故事继续
被感染的人也可能会注意到,在发烧开始三到七天后,“从耳朵后面和脸上开始,向身体扩散,然后蔓延到手臂和腿部”。
卡尔加里大学微生物学、免疫学和传染病学教授克雷格·珍妮博士说,这种空气传播的病毒即使不是医生们今天处理的“最具传染性的病毒”,也是其中之一。
更多关于健康的视频 温哥华集会提高人们对COVID的认识
温哥华集会提高人们对COVID的认识 卡尔加里地区确诊麻疹病例引起公众警惕
卡尔加里地区确诊麻疹病例引起公众警惕 安大略省精神卫生部长就如何解决该省的危机发表了讲话
安大略省精神卫生部长就如何解决该省的危机发表了讲话 女性大脑健康
女性大脑健康
“例如,如果有人进入一个商业或学校的地方,然后离开,病毒可能在他们离开后的几个小时内在空气中,甚至一个小时后进入该空间的人可能暴露并吸入病毒,甚至被感染,”珍妮博士说。
现在的趋势
对于那些认为自己可能接触过这种病毒的人,建议他们仔细检查自己是否接种了两剂麻疹疫苗,任何出现症状的人都被要求呆在家里,并在向任何医疗服务提供者寻求医疗服务之前拨打811健康热线。
据珍妮博士说,预防这种病毒的最好办法是接种疫苗。然而,他说,90%的人需要完全接种群体免疫疫苗来阻止病毒的传播,他补充说,在阿尔伯塔省,“大多数地方的疫苗接种率远低于这个水平”,这使得病毒很容易传播。
下面的故事继续
“我们往往低估了它的严重程度,”珍妮博士说。
他补充说:“一定比例的麻疹患者需要住院治疗,有些人需要重症监护病房治疗,可悲的是,正如我们去年在安大略省和美国南部看到的那样,人们可能会因这种感染而丧生。”